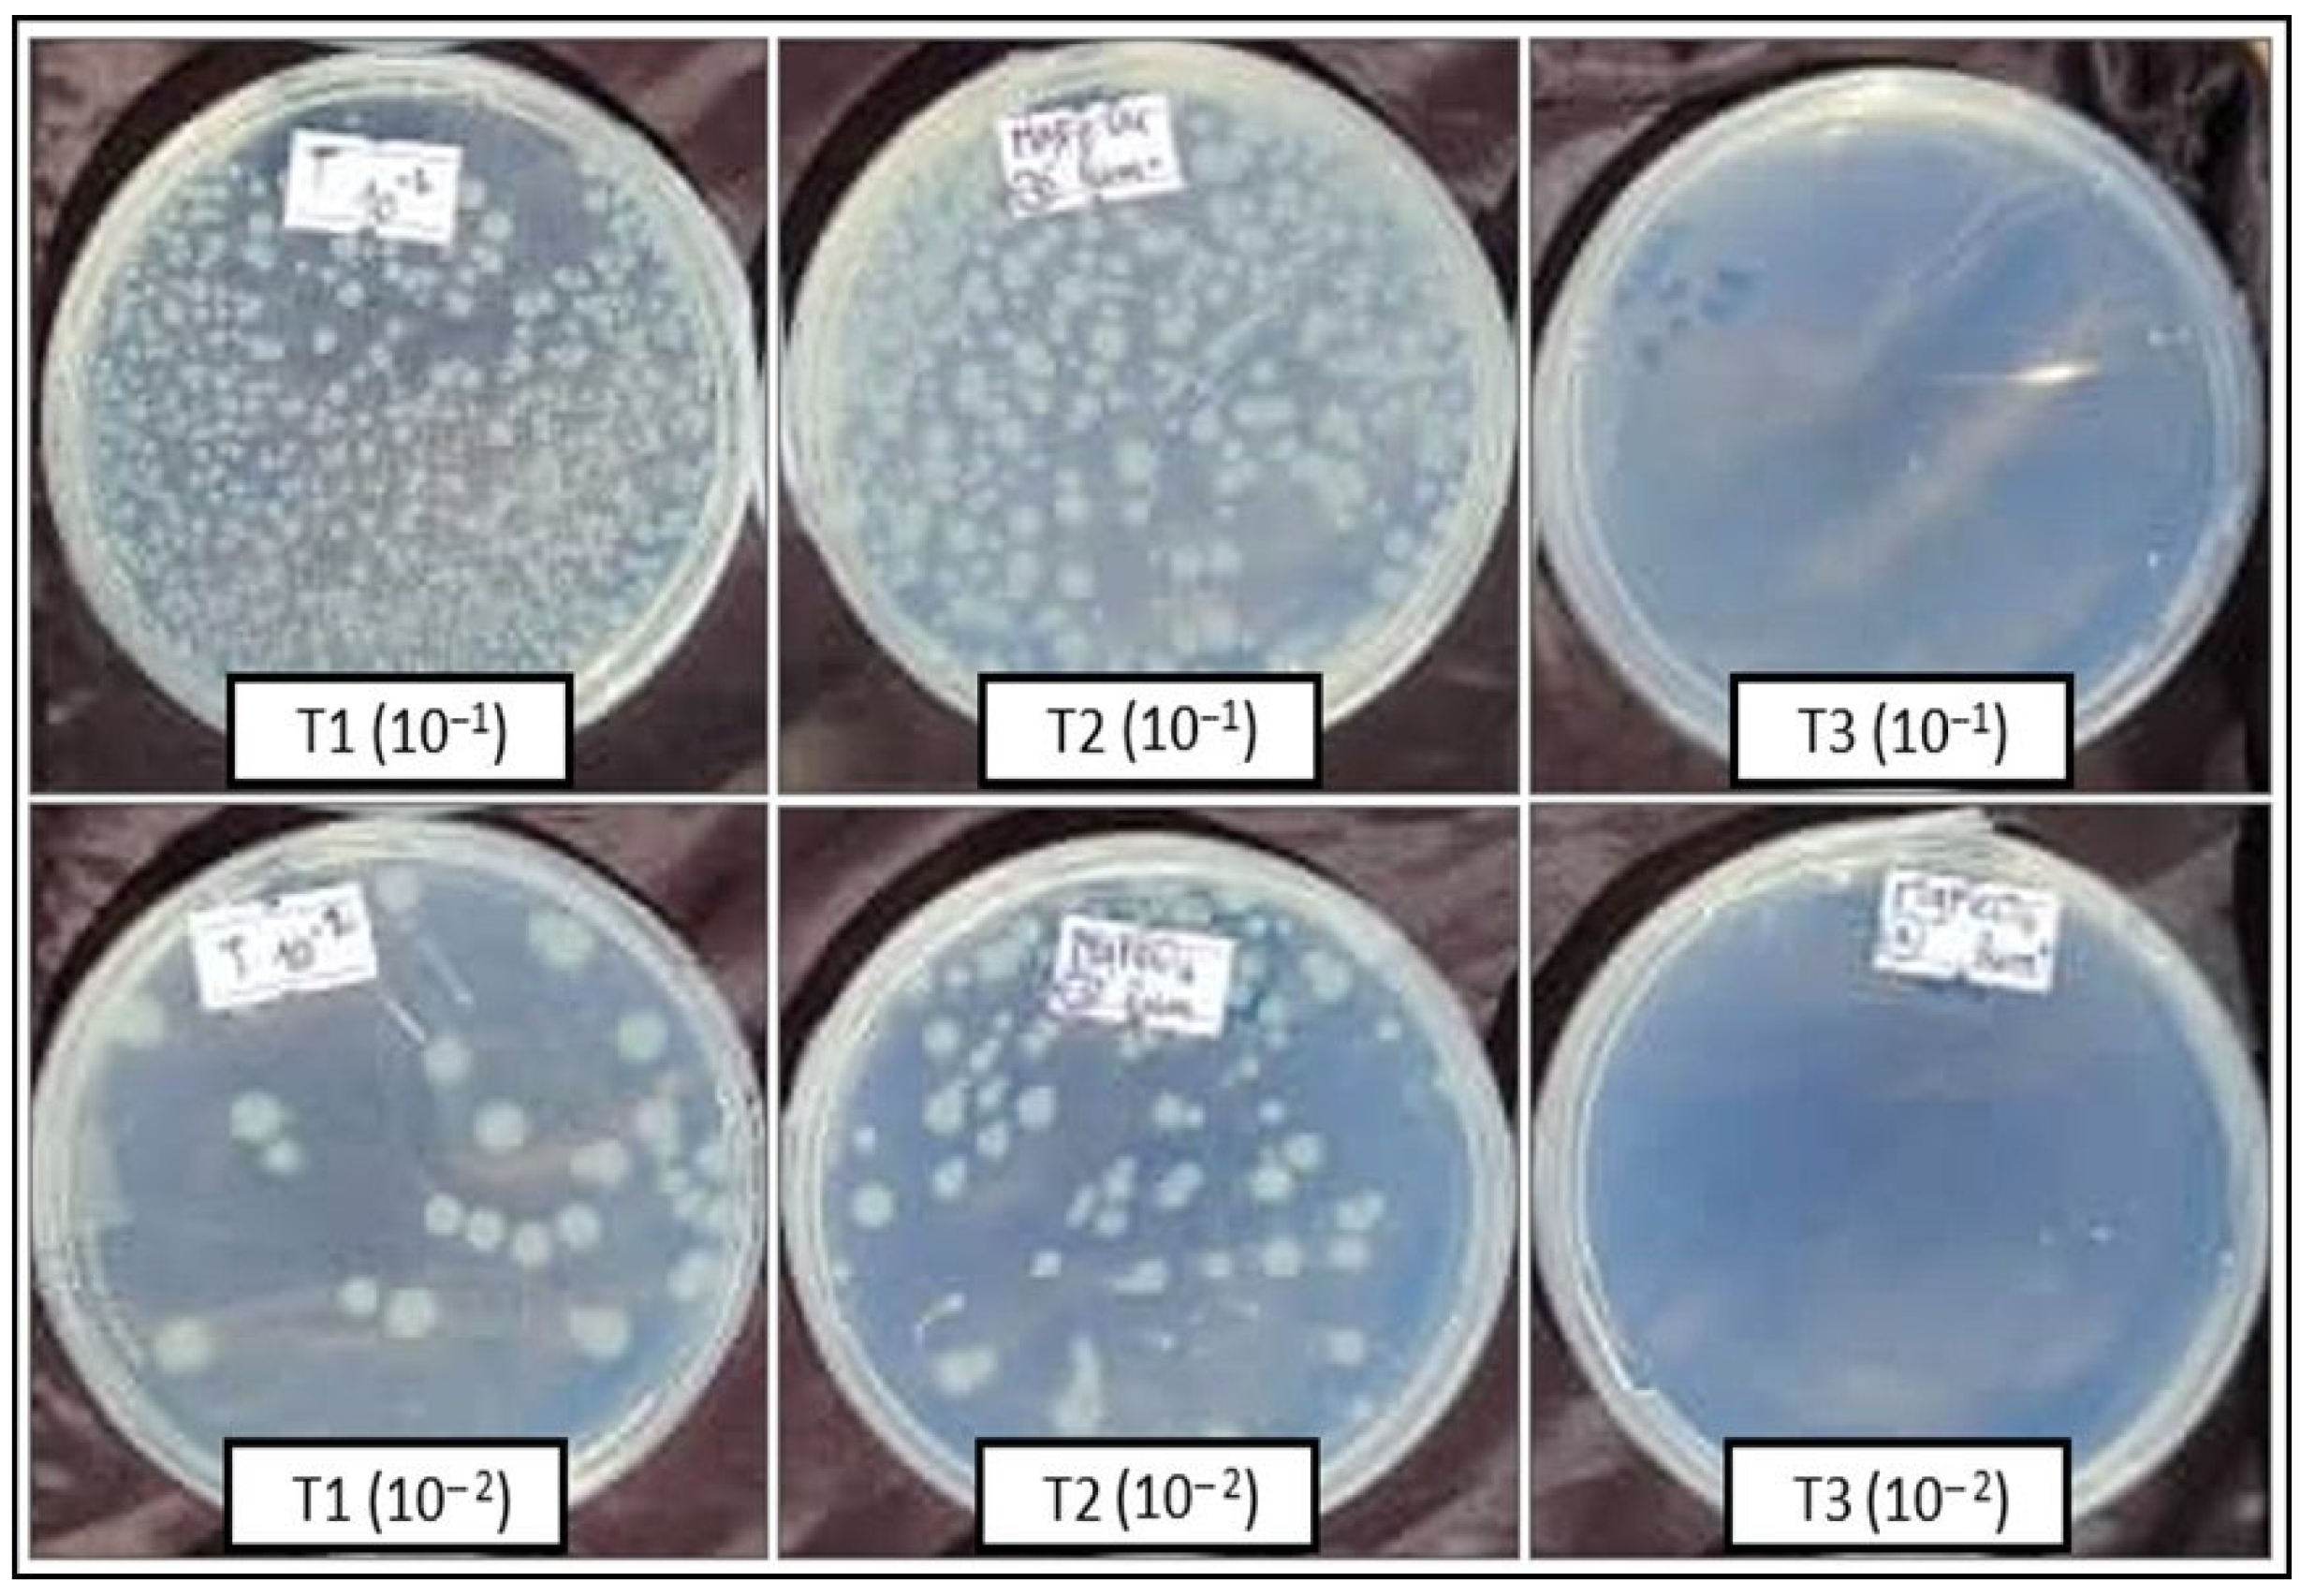

Innovative Antibacterial Air Filters Impregnated with Photocatalytic MgFe2O4 Nanoparticles for Improved Microbiological Air Quality
Abstract
1. Introduction
2. Results
2.1. Material Characterization
2.1.1. X-Ray Diffraction
2.1.2. Fourier Transform Infrared Spectroscopy (FTIR)
2.1.3. Scanning Electron Microscopy (SEM) and Transmission Electron Microscopy (TEM)
2.1.4. BET Analysis
2.1.5. X-Ray Photoelectron Spectroscopy (XPS) Analysis
2.2. Photocatalytic Degradation of Crystal Violet (CV)
2.3. Antibacterial Activity Against Escherichia coli ATCC 8739
2.4. Antibacterial Activity of Air Filters in the Air Circulation System
2.4.1. LB Solid Medium
2.4.2. LB Liquid Medium
- a.
- Direct measurement of the optical density of the LB liquid media
- b.
- Colony-forming Units (UFCs) numbering from the liquid LB media
3. Materials and Methods
3.1. Chemicals
3.2. Biological Material
3.3. MgFe2O4 Synthesis
3.4. MgFe2O4 Characterization
3.5. Photocatalytic Activity of MgFe2O4
3.6. Results of the Antibacterial Activity Against Escherichia coli
3.7. Air Pollution Control
3.7.1. Air Filter Fabrication
3.7.2. Construction of the Air Circulation System
3.8. Statistical Analysis
4. Conclusions
Author Contributions
Funding
Data Availability Statement
Acknowledgments
Conflicts of Interest
References
- Lascoumes, P. Les instruments d’action publique, traceurs de changement: L’exemple des transformations de la politique française de lutte contre la pollution atmosphérique (1961–2006). Polit. Soc. 2007, 26, 73–89. [Google Scholar] [CrossRef]
- Voronina, Y.; Lopushynskyi, I.; Grechanyk, B.; Vahonova, O.; Kondur, A.; Akimov, O. Economic and environmental component in the field of sustainable development management. Calitatea 2024, 25, 7–14. [Google Scholar]
- Schwarzenbach, R.P.; Egli, T.; Hofstetter, T.B.; Von Gunten, U.; Wehrli, B. Global water pollution and human health. Annu. Rev. Environ. Resour. 2010, 35, 109–136. [Google Scholar] [CrossRef]
- Chaitanya, M.V.N.L.; Arora, S.; Pal, R.S.; Ali, H.S.; El Haj, B.M.; Logesh, R. Assessment of environmental pollutants for their toxicological effects on human and animal health. In Organic Micropollutants in Aquatic and Terrestrial Environments; Springer: Cham, Switzerland, 2024; pp. 67–85. [Google Scholar]
- Sharma, G.; Verma, A.; Wang, T.; Naushad, M.; Kumar, A.; Dhiman, P. Remediation of antibiotics using coordination polymers. Coord. Chem. Rev. 2024, 519, 216120. [Google Scholar] [CrossRef]
- World Health Organization. Antimicrobial Resistance: Global Report on Surveillance; World Health Organization: Geneva, Switzerland, 2014; Available online: https://apps.who.int/iris/handle/10665/112642 (accessed on 22 February 2025).
- Halawa, E.M.; Fadel, M.; Al-Rabia, M.W.; Behairy, A.; Nouh, N.A.; Abdo, M.; Abdeen, A. Antibiotic action and resistance: Updated review of mechanisms, spread, influencing factors, and alternative approaches for combating resistance. Front. Pharmacol. 2024, 14, 1305294. [Google Scholar] [CrossRef]
- Mata, T.M.; Martins, A.A.; Calheiros, C.S.C.; Villanueva, F.; Alonso-Cuevilla, N.P.; Gabriel, M.F.; Silva, G.V. Indoor air quality: A review of cleaning technologies. Environments 2022, 9, 118. [Google Scholar] [CrossRef]
- Nguyen, M.; Burciaga, B.; Ghosh, N. History of Implementation of Nanotechnology in Novel Air Purifiers with Special Reference to Reduction of Pollen, Mold Spores, and PM2.5 Indices; West Texas A&M University: Canyon, TX, USA, 2024; Available online: https://wtamu-ir.tdl.org/items/0c9854cf-7203-4616-849f-6a9fcf546055 (accessed on 22 February 2025).
- Rodríguez, M.; Seseña, S.; Valiente, N.; Palop, L.; Rodríguez, A. Indoor air quality in elderly care centers: A multidisciplinary approach. Build. Environ. 2024, 262, 111832. [Google Scholar] [CrossRef]
- Donnet, M.; Mensi, M.; Lussi, A. La contamination bactérienne de l’air ambiant lors d’un traitement AIRFLOW®. Swiss Dent. J. SSO 2020, 130, 913–916. [Google Scholar]
- Morawska, L.; Johnson, G.R.; Ristovski, Z.D.; Hargreaves, M.; Mengersen, K.; Corbett, S.; Chao, C.Y.H.; Li, Y.; Katoshevski, D. Size distribution and sites of origin of droplets expelled from the human respiratory tract during expiratory activities. J. Aerosol Sci. 2009, 40, 256–269. [Google Scholar] [CrossRef]
- Gupta, J.K.; Lin, C.-H.; Chen, Q. Characterizing exhaled airflow from breathing and talking. Indoor Air 2010, 20, 31–39. [Google Scholar] [CrossRef]
- Matys, J.; Kensy, J.; Gedrange, T.; Zawiślak, I.; Grzech-Leśniak, K.; Dobrzyński, M. A molecular approach for detecting bacteria and fungi in healthcare environment aerosols: A systematic review. Int. J. Mol. Sci. 2024, 25, 4154. [Google Scholar] [CrossRef] [PubMed]
- World Health Organization. Air Pollution and Child Health: Prescribing Clean Air: Summary; World Health Organization: Geneva, Switzerland, 2018; WHO/CED/PHE/18.01; Available online: https://iris.who.int/handle/10665/275545 (accessed on 22 February 2025).
- Baranovsky, S. Circulation et Persistance de Pathogènes Nosocomiaux Multirésistants et Hautement Résistants Émergents dans l’environnement Hospitalier: Complexité des Unités de Transmission. Ph.D. Thesis, University of Montpellier, Montpellier, France, 2020. Available online: https://theses.hal.science/tel-03118483 (accessed on 22 February 2025).
- Gattinger, D.; Schlenz, V.; Weil, T.; Sattler, B. From remote to urbanized: Dispersal of antibiotic-resistant bacteria under the aspect of anthropogenic influence. Sci. Total Environ. 2024, 924, 171532. [Google Scholar] [CrossRef] [PubMed]
- Jann, J. Développement d’une Technologie de Surface Bactéricide à Base d’aluminium. Ph.D. Thesis, University of Sherbrooke, Sherbrooke, QC, Canada, 2023. Available online: https://savoirs.usherbrooke.ca/bitstream/11143/20032/18/jann_jessica_PhD_2023.pdf (accessed on 22 February 2025).
- Boudraa, R.; Talantikite-Touati, D.; Souici, A.; Djermoune, A.; Saidani, A.; Fendi, K.; Amrane, A.; Bollinger, J.C.; Tran, H.N.; Hadadi, A.; et al. Optical and photocatalytic properties of TiO2–Bi2O3–CuO supported on natural zeolite for removing Safranin-O dye from water and wastewater. J. Photochem. Photobiol. A Chem. 2023, 443, 114845. [Google Scholar] [CrossRef]
- Cheikh, S.; Imessaoudene, A.; Bollinger, J.-C.; Hadadi, A.; Manseri, A.; Bouzaza, A.; Assadi, A.; Amrane, A.; Zamouche, M.; El Jery, A.; et al. Complete Elimination of the Ciprofloxacin Antibiotic from Water by the Combination of Adsorption–Photocatalysis Process Using Natural Hydroxyapatite and TiO2. Catalysts 2023, 13, 336. [Google Scholar] [CrossRef]
- Imessaoudene, A.; Mechraoui, O.; Aberkane, B.; Benabbas, A.; Manseri, A.; Moussaoui, Y.; Bollinger, J.C.; Amrane, A.; Zoukel, A.; Mouni, L. Synthesis of a TiO2/zeolite composite: Evaluation of adsorption-photodegradation synergy for the removal of Malachite Green. Nano-Struct. Nano-Objects 2024, 38, 101191. [Google Scholar] [CrossRef]
- Boudraa, R.; Talantikite-Touati, D.; Souici, A.; Djermoune, A.; Saidani, A.; Fendi, K.; Amrane, A.; Bollinger, J.C.; Tran, H.N.; Mouni, L. Breaking new grounds: Solid-state synthesis of TiO2–La2O3–CuO nanocomposites for degrading brilliant green dye under visible light. J. Clean. Prod. 2024, 481, 144126. [Google Scholar] [CrossRef]
- Boudraa, R.; Talantikite-Touati, D.; Djermoune, A.; Souici, A.; Kebir, M.; Ait Merzeg, F.; Amrane, A.; Bollinger, J.C.; Mouni, L. Comprehensive characterization and unprecedented photocatalytic efficacy of TiO2-CuO-La2O3 and TiO2-CuO-Bi2O3 nanocomposites: A novel approach to environmental remediation. Mater. Sci. Eng. B 2025, 312, 117863. [Google Scholar] [CrossRef]
- Sánchez-Bayo, F. Impacts of agricultural pesticides on terrestrial ecosystems. In Ecological Impacts of Toxic Chemicals; Sánchez-Bayo, F., van den Brink, P.J., Mann, R.M., Eds.; Bentham Science Publishers: Sharjah, United Arab Emirates, 2011; pp. 63–87. [Google Scholar] [CrossRef][Green Version]
- Arain, M.F. Nanotools for air remediation: An introduction. In Nanotechnology to Monitor, Remedy, and Prevent Pollution; Arain, M.F., Ed.; Elsevier: Amsterdam, The Netherlands, 2024; pp. 125–140. [Google Scholar] [CrossRef]
- Rai, M.; Yadav, A.; Gade, A. Silver nanoparticles as a new generation of antimicrobials. Biotechnol. Adv. 2009, 27, 76–83. [Google Scholar] [CrossRef]
- Fatolahi, L. Evaluation of photocatalysis inactivation in indoor air purification of pathogenic microbes by using the different nanomaterials based on TiO2 nanomaterials. J. Environ. Sci. Health A 2024, 59, 213–222. [Google Scholar] [CrossRef]
- El-Khawaga, A.M.; Ayman, M.; Hafez, O.; Shalaby, R.E. Photocatalytic, Antimicrobial and Antibiofilm Activities of MgFe2O4 Magnetic Nanoparticles. Sci. Rep. 2024, 14, 12877. [Google Scholar] [CrossRef]
- Sajid, S.; Kodape, S.M.; Kurhade, P. A study on bacterial inactivation using green synthesized photocatalytically active TiO2, MgO, TiO2/MgO nanoparticles. J. Indian Chem. Soc. 2024, 101, 101425. [Google Scholar] [CrossRef]
- Beena, V.; Parvathiraja, C.; Paulkumar, K.; Gupta, J.K.; Almutairi, T.M.; Mouni, L. Bio-engineered NiO nanoparticles for photocatalytic and antibacterial treatments. J. Dispers. Sci. Technol. 2025, 1–13. [Google Scholar] [CrossRef]
- Sun, S.; Zeng, H. Size-controlled synthesis of magnetite nanoparticles. J. Am. Chem. Soc. 2002, 124, 8204–8205. [Google Scholar] [CrossRef]
- Laurent, S.; Forge, D.; Port, M.; Roch, A.; Robic, C.; Vander Elst, L.; Muller, R.N. Magnetic iron oxide nanoparticles: Synthesis, stabilization, vectorization, physicochemical characterizations, and biological applications. Chem. Rev. 2008, 108, 2064–2110. [Google Scholar] [CrossRef]
- Manohar, A.; Suvarna, T.; Vattikuti, S.V.P.; Manivasagan, P.; Jang, E.S.; Sudhani, H.P.; Kim, K.H. Structural, morphological, magnetic, electrochemical and biocompatible properties of ZnFe2O4/MgFe2O4/NiFe2O4/CeO2 nanocomposites. Colloids Surf. A Physicochem. Eng. Asp. 2024, 705, 135667. [Google Scholar] [CrossRef]
- Choi, W.; Termin, A.; Hoffmann, M.R. The role of metal ion dopants in quantum-sized TiO2: Correlation between photoreactivity and charge carrier recombination dynamics. J. Phys. Chem. 1994, 98, 13669–13679. [Google Scholar] [CrossRef]
- Guo, X.; Yang, Z.; Dong, H.; Guan, X.; Ren, Q.; Lv, X.; Jin, X. Simple combination of oxidants with zero-valent iron (ZVI) achieved very rapid and highly efficient removal of heavy metals from water. Water Res. 2016, 88, 671–680. [Google Scholar] [CrossRef]
- Huang, Y.; Ho, S.S.H.; Lu, Y.; Niu, R.; Xu, L.; Cao, J.; Lee, S. Removal of Indoor Volatile Organic Compounds via Photocatalytic Oxidation: A Short Review and Prospect. Molecules 2016, 21, 56. [Google Scholar] [CrossRef]
- Laouici, R. Élaboration des Matériaux Semi-Conducteurs et Étude de Leurs Applications Environnementales. Ph.D. Thesis, University of Jijel, Jijel, Algeria, 2023. [Google Scholar]
- Simon-Deckers, A. Biological Effects of Manufactured Nanoparticles: Influence of Their Characteristics. Ph.D. Thesis, AgroParisTech, Paris, France, 2008. [Google Scholar]
- Salih, S.J.; Mahmood, W.M. Review on magnetic spinel ferrite (MFe2O4) nanoparticles: From synthesis to application. Heliyon 2023, 9, e16601. [Google Scholar] [CrossRef]
- Nie, C.; Qiu, Y.; Pei, T.; Qin, Y. Specific Sources Exert Influence on the Community Structures of Bioaerosols. Aerobiology 2024, 2, 72–84. [Google Scholar] [CrossRef]
- Hart, D. Pathogenic Bacteria in the Air of Operating Rooms: Their Widespread Distribution and the Methods of Control. Arch. Surg. 1938, 37, 521–530. [Google Scholar] [CrossRef]
- Stryjakowska-Sekulska, M.; Piotraszewska-Pajak, A.; Szyszka, A.; Nowicki, M.; Filipiak, M. Microbiological Quality of Indoor Air in University Rooms. Pol. J. Environ. Stud. 2007, 16, 623. [Google Scholar]
- Brągoszewska, E.; Biedroń, I. Indoor Air Quality and Potential Health Risk Impacts of Exposure to Antibiotic-Resistant Bacteria in Office Rooms in Southern Poland. Int. J. Environ. Res. Public Health 2018, 15, 2604. [Google Scholar] [CrossRef] [PubMed]
- Jonidi Jafari, A.; Moslemzadeh, M. The Effect of TiO₂ Nanoparticles on Bacterial Growth: The Effect of Particle Size and Their Structure—A Systematic Review. Int. J. Environ. Health Res. 2024, 34, 697–707. [Google Scholar] [CrossRef]
- Salas-Orozco, M.F.; Lorenzo-Leal, A.C.; de Alba Montero, I.; Marín, N.P.; Santana, M.A.C.; Bach, H. Mechanism of Escape from the Antibacterial Activity of Metal-Based Nanoparticles in Clinically Relevant Bacteria: A Systematic Review. Nanomedicine 2024, 55, 102715. [Google Scholar] [CrossRef]
- Le Ouay, B.; Stellacci, F. Antibacterial Activity of Silver Nanoparticles: A Surface Science Insight. Nano Today 2015, 10, 339–354. [Google Scholar] [CrossRef]
- Dutta, S.; Erchinger, J.E.; Strieth-Kalthoff, F.; Kleinmans, R.; Glorius, F. Energy Transfer Photocatalysis: Exciting Modes of Reactivity. Chem. Soc. Rev. 2024, 53, 1068–1089. [Google Scholar] [CrossRef]
- Tessema, B.; Gonfa, G.; Hailegiorgis, S.M.; Workneh, G.A.; Tadesse, T.G. Synthesis and Evaluation of the Anti-Bacterial Effect of Modified Silica Gel Supported Silver Nanoparticles on E. coli and S. aureus. Results Chem. 2024, 7, 101471. [Google Scholar] [CrossRef]
- Morones, J.R.; Elechiguerra, J.L.; Camacho, A.; Holt, K.; Kouri, J.B.; Ramírez, J.T.; Yacaman, M.J. The Bactericidal Effect of Silver Nanoparticles. Nanotechnology 2005, 16, 2346–2353. [Google Scholar] [CrossRef]
- Rai, M.; Kon, K.; Ingle, A.; Duran, N.; Galdiero, S.; Galdiero, M. Broad-Spectrum Bioactivities of Silver Nanoparticles: The Emerging Trends and Future Prospects. Appl. Microbiol. Biotechnol. 2014, 98, 1951–1961. [Google Scholar] [CrossRef]
- Ivask, A.; Juganson, K.; Bondarenko, O.; Mortimer, M.; Aruoja, V.; Kasemets, K.; Blinova, I.; Heinlaan, M.; Slaveykova, V.; Kahru, A. Mechanisms of Toxic Action of Ag, ZnO and CuO Nanoparticles to Selected Ecotoxicological Test Organisms and Mammalian Cells In Vitro: A Comparative Review. Nanotoxicology 2014, 8 (Suppl. S1), 57–71. [Google Scholar] [CrossRef] [PubMed]
- Bortolassi, A.C.C.; Nagarajan, S.; de Araújo Lima, B.; Guerra, V.G.; Aguiar, M.L.; Huon, V.; Soussan, L.; Cornu, D.; Miele, P.; Bechelany, M. Efficient Nanoparticles Removal and Bactericidal Action of Electrospun Nanofibers Membranes for Air Filtration. Mater. Sci. Eng. C 2019, 102, 718–729. [Google Scholar] [CrossRef] [PubMed]
- Fayez, K.A.; El-Deeb, B.A.; Mostafa, N.Y. Toxicity of Biosynthetic Silver Nanoparticles on the Growth, Cell Ultrastructure and Physiological Activities of Barley Plant. Acta Physiol. Plant. 2017, 39, 155. [Google Scholar] [CrossRef]
- Xiu, Z.M.; Zhang, Q.B.; Puppala, H.L.; Colvin, V.L.; Alvarez, P.J.J. Negligible Particle-Specific Antibacterial Activity of Silver Nanoparticles. Nano Lett. 2012, 12, 4271–4275. [Google Scholar] [CrossRef]
- Da Costa, D. Développement D’une Thérapie Combinatoire à Base D’agents Anti-Biofilms et de Particules D’acide Poly-Lactique Pour la Délivrance D’antibiotiques Contre des Biofilms Bactériens. Ph.D. Thesis, University of Lyon, Lyon, France, 2020. Available online: https://theses.hal.science/tel-03612040 (accessed on 22 February 2025).
- Jomini, S. Effets des Nanoparticules de Dioxyde de Titane Sur Les Bactéries: De la Cellule à la Communauté. Ph.D. Thesis, University of Lorraine, Nancy, France, 2014. Available online: https://hal.univ-lorraine.fr/tel-01750816 (accessed on 22 February 2025).
- Uddin, M.J.; Jeong, Y.K. Application of Magnesium Ferrite Nanomaterials for Adsorptive Removal of Arsenic from Water: Effects of Mg and Fe Ratio. Chemosphere 2022, 307, 135817. [Google Scholar] [CrossRef]
- Manohar, A.; Vijayakanth, V.; Reddy Pallavolu, M.; Hyeon Kim, K. Effects of Ni-Substitution on Structural, Magnetic Hyperthermia, Photocatalytic, and Cytotoxicity Study of MgFe2O4 Nanoparticles. J. Alloys Compd. 2021, 868, 160515. [Google Scholar] [CrossRef]
- Ilhan, S.; Izotova, S.G.; Komlev, A.A. Synthesis and Characterization of MgFe2O4 Nanoparticles Prepared by Hydrothermal Decomposition of Co-Precipitated Magnesium and Iron Hydroxides. Ceram. Int. 2015, 41, 577–585. [Google Scholar] [CrossRef]
- Phenrat, T.; Saleh, N.; Sirk, K.; Tilton, R.D.; Lowry, G.V. Aggregation and Sedimentation of Aqueous Nanoscale Zerovalent Iron Dispersions. Environ. Sci. Technol. 2007, 41, 284–290. [Google Scholar] [CrossRef]
- de Hoyos-Sifuentes, D.H.; Reséndiz-Hernández, P.J.; Díaz-Guillén, J.A.; Ochoa-Palacios, R.M.; Altamirano-Guerrero, G. Synthesis and Characterization of MgFe2O4 Nanoparticles and PEG-Coated MgFe2O4 Nanocomposite. J. Mater. Res. Technol. 2022, 18, 3130–3142. [Google Scholar] [CrossRef]
- Uma, S.; Vignesh, D.; Shobana, M.K. Synthesis of heterostructured nanocomposite MgFe2O4/MoO3 for H2S sensing: Experimental and theoretical approach by DFT. Sens. Actuators B Chem. 2025, 425, 136950. [Google Scholar] [CrossRef]
- Padhan, A.M.; Nayak, S.; Sahu, M.; Jagličić, Z.; Koželj, P.; Kim, H.J. Cationic redistribution induced magnetic properties of Zn²⁺ substituted MgFe₂O₄ spinel ferrite. Phys. B Condens. Matter 2023, 668, 415245. [Google Scholar] [CrossRef]
- Zhao, L.; Li, X.; Zhao, Q.; Qu, Z.; Yuan, D.; Liu, S.; Hu, X.; Chen, G. Synthesis, characterization and adsorptive performance of MgFe2O4 nanospheres for SO2 removal. J. Hazard. Mater. 2010, 184, 704–709. [Google Scholar] [CrossRef] [PubMed]
- Taha, T.A.; Fayed, M.G.; Mohamed, S.G. Enhanced electrochemical performance of MgFe2O4/SrTiO3 and MgFe2O4/SiO2 nanocomposite structures. J. Alloys Compd. 2022, 925, 166660. [Google Scholar] [CrossRef]
- Kaur Ubhi, M.; Kaur, M.; Singh, D.; Javed, M.; Oliveira, A.C.; Kumar Garg, V.; Sharma, V.K. Hierarchical Nanoflowers of MgFe2O4, Bentonite and B-,P- Co-Doped Graphene Oxide as Adsorbent and Photocatalyst: Optimization of Parameters by Box–Behnken Methodology. Int. J. Mol. Sci. 2022, 23, 9678. [Google Scholar] [CrossRef]
- Heiba, Z.K.; Sanad, M.M.S.; Mohamed, M.B. Influence of Mg-deficiency on the functional properties of magnesium ferrite anode material. Solid State Ion. 2019, 341, 115042. [Google Scholar] [CrossRef]
- Yan, Z.; Gao, J.; Li, Y.; Zhang, M.; Guo, M. Hydrothermal synthesis and structure evolution of metal-doped magnesium ferrite from saprolite laterite. RSC Adv. 2015, 5, 92778–92787. [Google Scholar] [CrossRef]
- Kim, J.H.; Jang, Y.J.; Kim, J.H.; Jang, J.W.; Choi, S.H.; Lee, J.S. Defective ZnFe2O4 nanorods with oxygen vacancy for photoelectrochemical water splitting. Nanoscale 2015, 7, 19144–19151. [Google Scholar] [CrossRef]
- Soukeur, A.; Kaci, M.; Omeiri, S.; Bellal, B.; Amara, M.; Trari, M. Photocatalytic degradation of bromothymol blue over MgFe2O4 under sunlight exposure. Opt. Mater. 2023, 142, 114108. [Google Scholar] [CrossRef]
- Rajadurai, L.; Dash, C.S.; Revathi, S.; Dhiwahar, A.T.; Sundararajan, M.; Ravisankar, P.; Alagarasan, J.K.; Mohandoss, S.; Sambasivam, R. Photocatalytic Degradation of Tetracycline Hydrochloride Using Pure and Copper-Doped Magnesium Ferrite Nanoparticles: Efficiency, Kinetics, and Mechanism. Inorg. Chem. Commun. 2024, 162, 112197. [Google Scholar] [CrossRef]
- Salama, R.S.; Gouda, M.S.; Aboud, M.F.A.; Alshorifi, F.T.; El-Hallag, A.A.; Badawi, A.K. Synthesis and Characterization of Magnesium Ferrite-Activated Carbon Composites Derived from Orange Peels for Enhanced Supercapacitor Performance. Sci. Rep. 2024, 14, 8223. [Google Scholar] [CrossRef]
- Dadi, R. Synthèse de Nanoparticules D’oxydes Métalliques et Leur Activité Antibactérienne. Ph.D. Thesis, Université Paris-Nord-Paris XIII, Villetaneuse, France, 2019. Available online: https://theses.hal.science/tel-03119316 (accessed on 22 February 2025).
- Sirelkhatim, A.; Mahmud, S.; Seeni, A.; Kaus, N.H.M.; Ann, L.C.; Bakhori, S.K.M.; Hasan, H.; Mohamad, D. Review on Zinc Oxide Nanoparticles: Antibacterial Activity and Toxicity Mechanism. Nano-Micro Lett. 2015, 7, 219–242. [Google Scholar] [CrossRef] [PubMed]
- Ryu, S.; Kim, D.; Lee, H.; Kim, Y.; Lee, Y.; Kim, M.; Kim, H.; Lee, H. Biodegradable Nanofiber/Metal–Organic Framework/Cotton Air Filtration Membranes Enabling Simultaneous Removal of Toxic Gases and Particulate Matter. Polymers 2023, 15, 3965. [Google Scholar] [CrossRef] [PubMed]
- Lagashetty, A.; Pattar, A.; Ganiger, S.K. Synthesis, Characterization and Antibacterial Study of Ag-Doped Magnesium Ferrite Nanocomposite. Heliyon 2019, 5, e01760. [Google Scholar] [CrossRef]
- Ehi-Eromosele, C.O.; Olugbuyiro, J.A.O.; Taiwo, O.S.; Bamgboye, O.A.; Ango, C.E. Synthesis and Evaluation of the Antimicrobial Potentials of Cobalt-Doped and Magnesium Ferrite Spinel Nanoparticles. Bull. Chem. Soc. Ethiop. 2018, 32, 451–458. [Google Scholar] [CrossRef]
- Kim, K.H.; Kabir, E.; Jahan, S.A. Airborne Bioaerosols and Their Impact on Human Health. J. Environ. Sci. 2018, 67, 23–35. [Google Scholar] [CrossRef]
- Bonfim, D.P.; Cruz, F.G.; Guerra, V.G.; Aguiar, M.L. Development of Filter Media by Electrospinning for Air Filtration of Nanoparticles from PET Bottles. Membranes 2021, 11, 293. [Google Scholar] [CrossRef]
- De Riccardis, M.F. Electrospun Nanofibrous Membranes for Air Filtration: A Critical Review. Compounds 2023, 3, 390–410. [Google Scholar] [CrossRef]
- Vilar, M.R.; Ferraria, A.M.; do Rego, A.M.B.; Boufi, S. Cellulose: De Nouvelles Perspectives pour un Matériau Millénaire. L’Actualité Chim. 2015, 393–394, 102. [Google Scholar]
- Zaich, Y.; Lourghi, A.; Rouibah, K.E.; Akika, F.Z. Adsorption et Photo-Dégradation sous Irradiation Solaire de Quelques Polluants Organiques Contenus dans les Effluents Liquides. Ph.D. Thesis, Université de Jijel, Jijel, Algeria, 2022. [Google Scholar]
- Rossano, M. Utilisation des Nanoparticules de Dioxyde de Titane dans les Émulsions Cosmétiques: Impact sur la Santé Humaine et l’Environnement. Ph.D. Thesis, Université Le Havre, Le Havre, France, 2014. Available online: https://theses.fr/2014LEHA0003 (accessed on 22 February 2025).
- Wolfram, J.; Zhu, M.; Yang, Y.; Shen, J.; Gentile, E.; Paolino, D.; Zhao, Y. Safety of Nanoparticles in Medicine. Curr. Drug Targets 2015, 16, 1671–1681. [Google Scholar] [CrossRef]
- Mao, N.; Russell, S.J.; Pourdeyhimi, B. Characterisation, Testing, and Modelling of Nonwoven Fabrics. In Handbook of Nonwovens; Woodhead Publishing: Sawston, UK, 2022; pp. 509–626. [Google Scholar] [CrossRef]
- Brugger, S.D.; Baumberger, C.; Jost, M.; Jenni, W.; Brugger, U.; Mühlemann, K. Automated Counting of Bacterial Colony Forming Units on Agar Plates. PLoS ONE 2012, 7, e33695. [Google Scholar] [CrossRef]

| T1 * (10−1) | T1 (10−2) | T2 ** (10−1) | T2 (10−2) | T3 *** (10−1) | T3 (10−2) | |
|---|---|---|---|---|---|---|
| Bacterial count (CFU) | ˃300 | 64 ± 32.741 | ˃ 300 | 112.33 ± 49.702 | 0.33 ± 0.577 | 0.00 |
| T1 * (10−1) | T1 (10−2) | T2 ** (10−1) | T2 (10−2) | T3 *** (10−1) | T3 (10−2) | |
|---|---|---|---|---|---|---|
| Optical density (600 nm) | 0.2781 ± 0.0437 | 0.2449 ± 0.0412 | 0.261 ± 0.0115 | 0.2695 ± 0.0167 | 0.00 | 0.00 |
Disclaimer/Publisher’s Note: The statements, opinions and data contained in all publications are solely those of the individual author(s) and contributor(s) and not of MDPI and/or the editor(s). MDPI and/or the editor(s) disclaim responsibility for any injury to people or property resulting from any ideas, methods, instructions or products referred to in the content. |
© 2025 by the authors. Licensee MDPI, Basel, Switzerland. This article is an open access article distributed under the terms and conditions of the Creative Commons Attribution (CC BY) license (https://creativecommons.org/licenses/by/4.0/).
Share and Cite
Rai, A.; Tebbi, S.O.; Ben Mahfoud, C.; Bourbala, M.; Boudraa, R.; Amrane, A.; Maaloul, N.; Rendueles, M.; Oulego, P.; Alharthi, M.N.; et al. Innovative Antibacterial Air Filters Impregnated with Photocatalytic MgFe2O4 Nanoparticles for Improved Microbiological Air Quality. Catalysts 2025, 15, 365. https://doi.org/10.3390/catal15040365
Rai A, Tebbi SO, Ben Mahfoud C, Bourbala M, Boudraa R, Amrane A, Maaloul N, Rendueles M, Oulego P, Alharthi MN, et al. Innovative Antibacterial Air Filters Impregnated with Photocatalytic MgFe2O4 Nanoparticles for Improved Microbiological Air Quality. Catalysts. 2025; 15(4):365. https://doi.org/10.3390/catal15040365
Chicago/Turabian StyleRai, Abdelwahab, Sara Oumenoune Tebbi, Chaima Ben Mahfoud, Maroua Bourbala, Reguia Boudraa, Abdelatif Amrane, Najeh Maaloul, Manuel Rendueles, Paula Oulego, Maymounah N. Alharthi, and et al. 2025. "Innovative Antibacterial Air Filters Impregnated with Photocatalytic MgFe2O4 Nanoparticles for Improved Microbiological Air Quality" Catalysts 15, no. 4: 365. https://doi.org/10.3390/catal15040365
APA StyleRai, A., Tebbi, S. O., Ben Mahfoud, C., Bourbala, M., Boudraa, R., Amrane, A., Maaloul, N., Rendueles, M., Oulego, P., Alharthi, M. N., & Mouni, L. (2025). Innovative Antibacterial Air Filters Impregnated with Photocatalytic MgFe2O4 Nanoparticles for Improved Microbiological Air Quality. Catalysts, 15(4), 365. https://doi.org/10.3390/catal15040365

